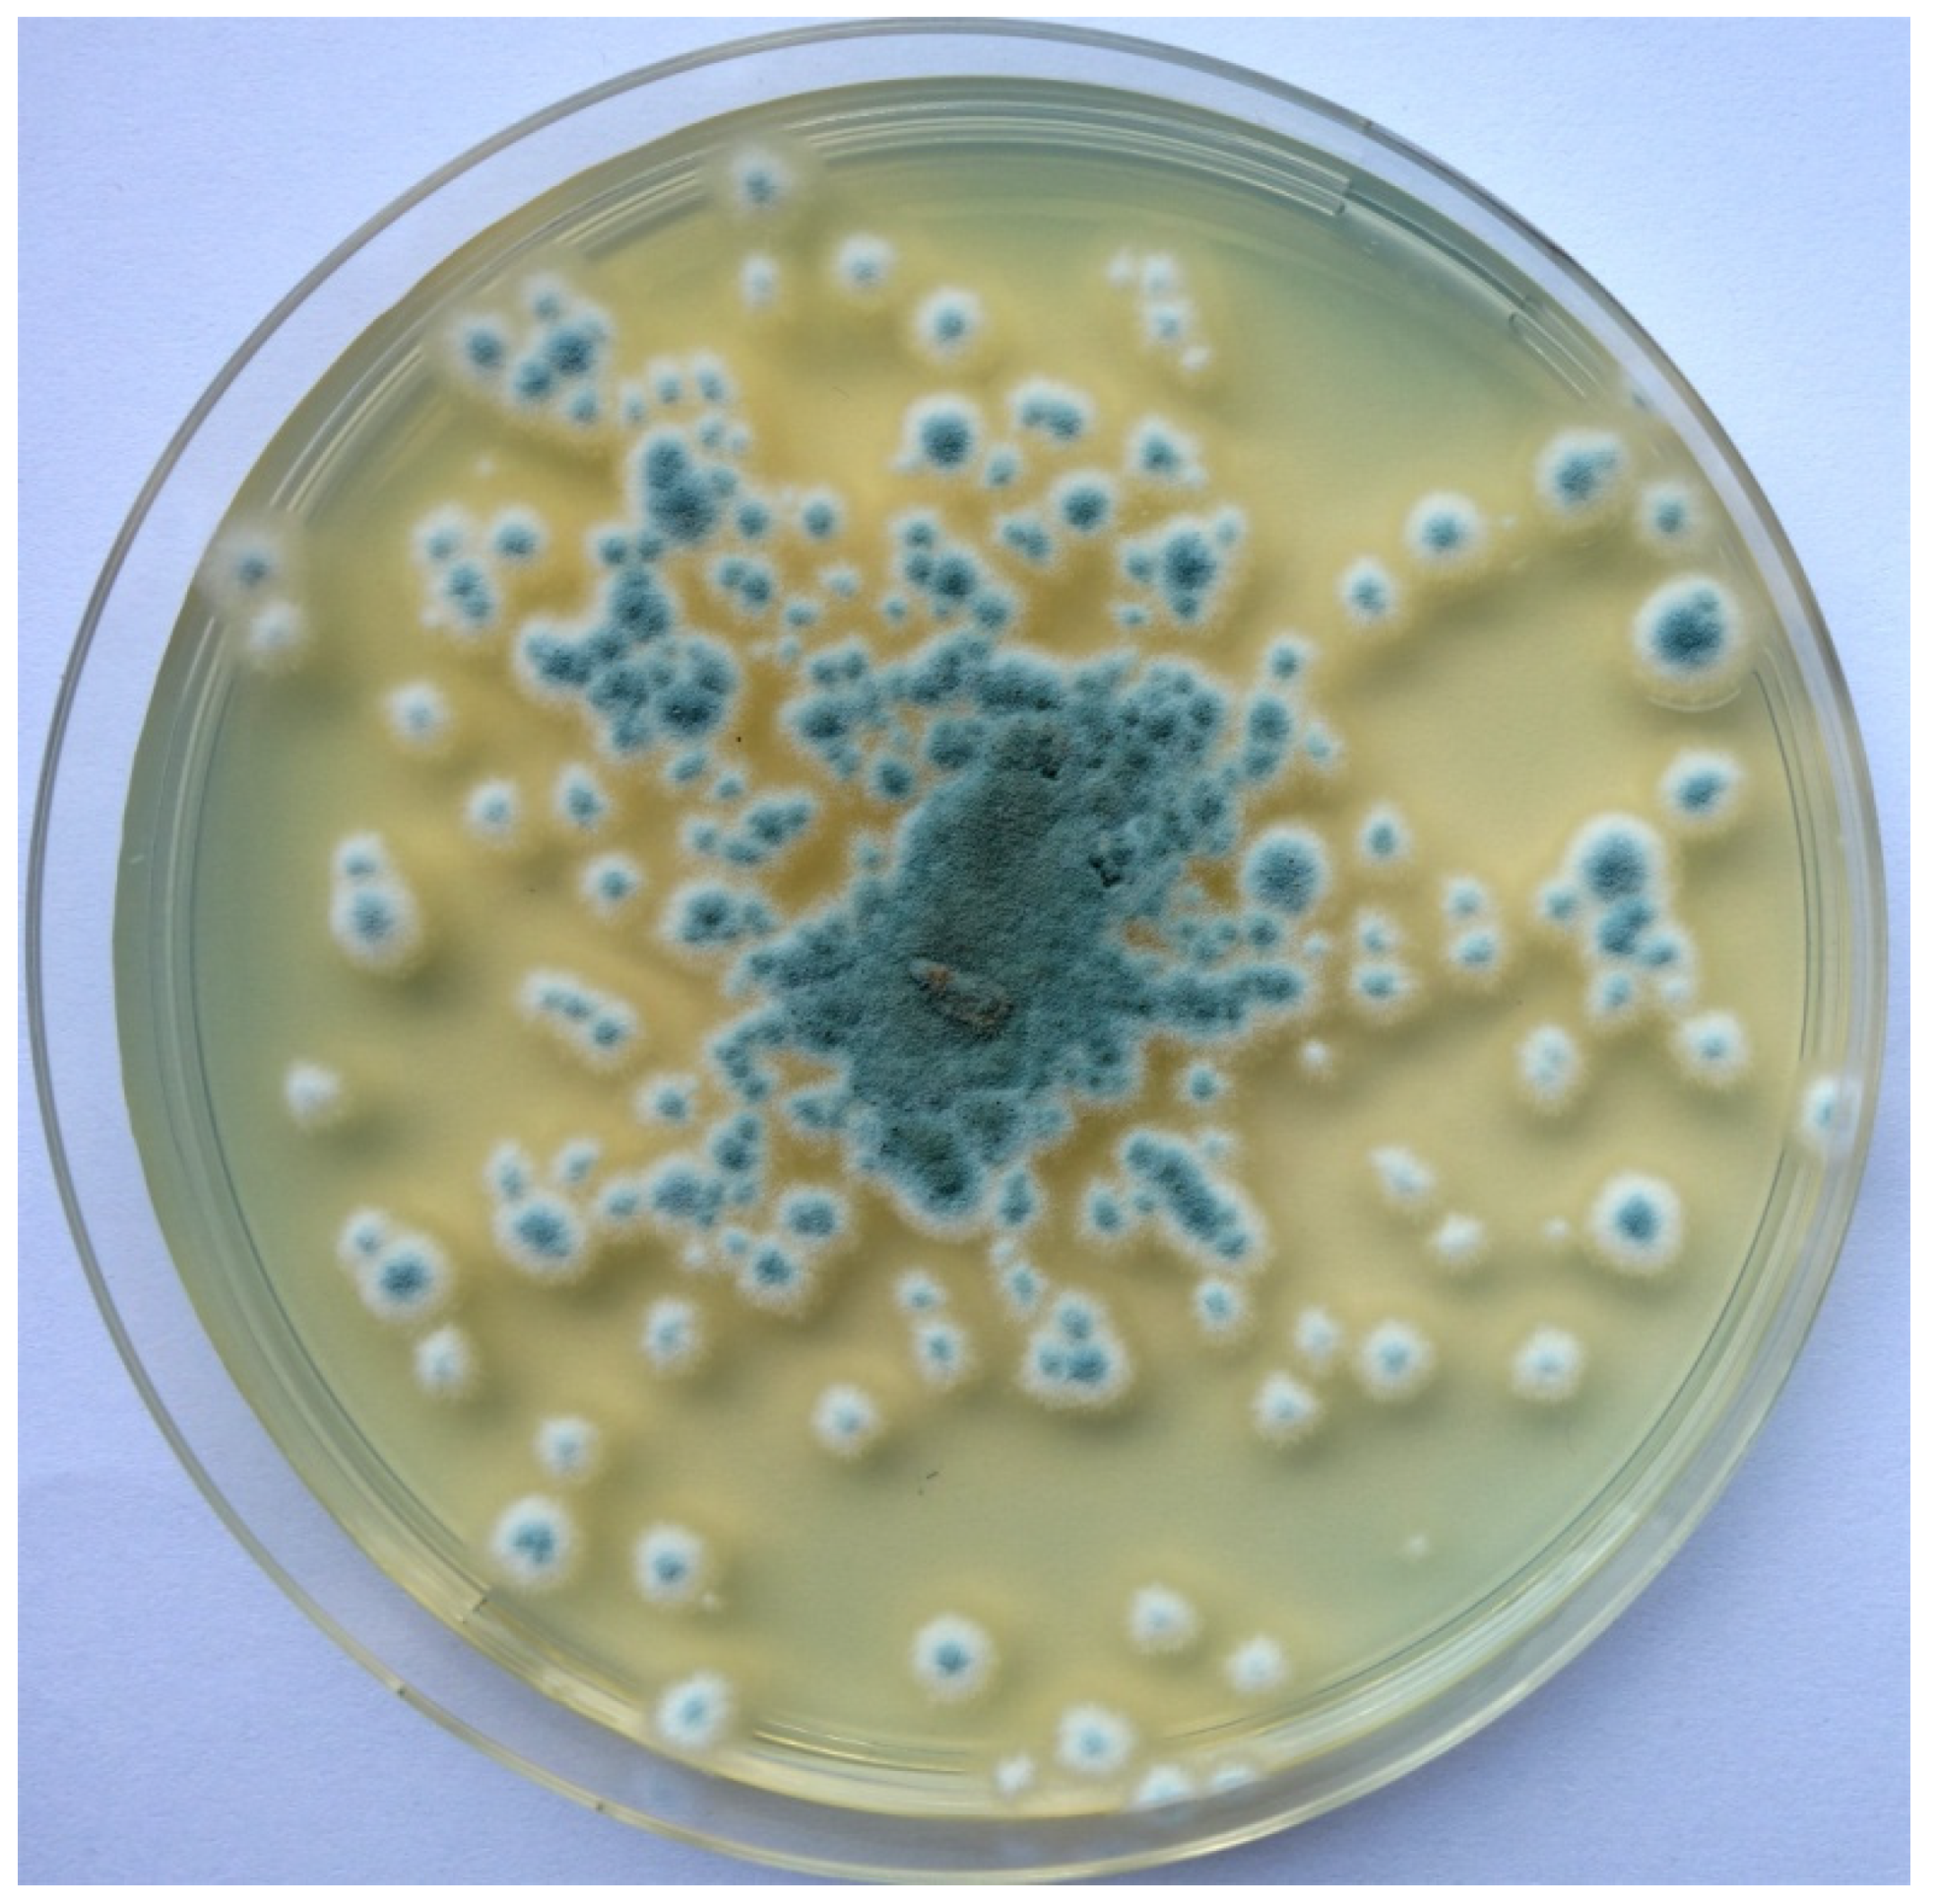
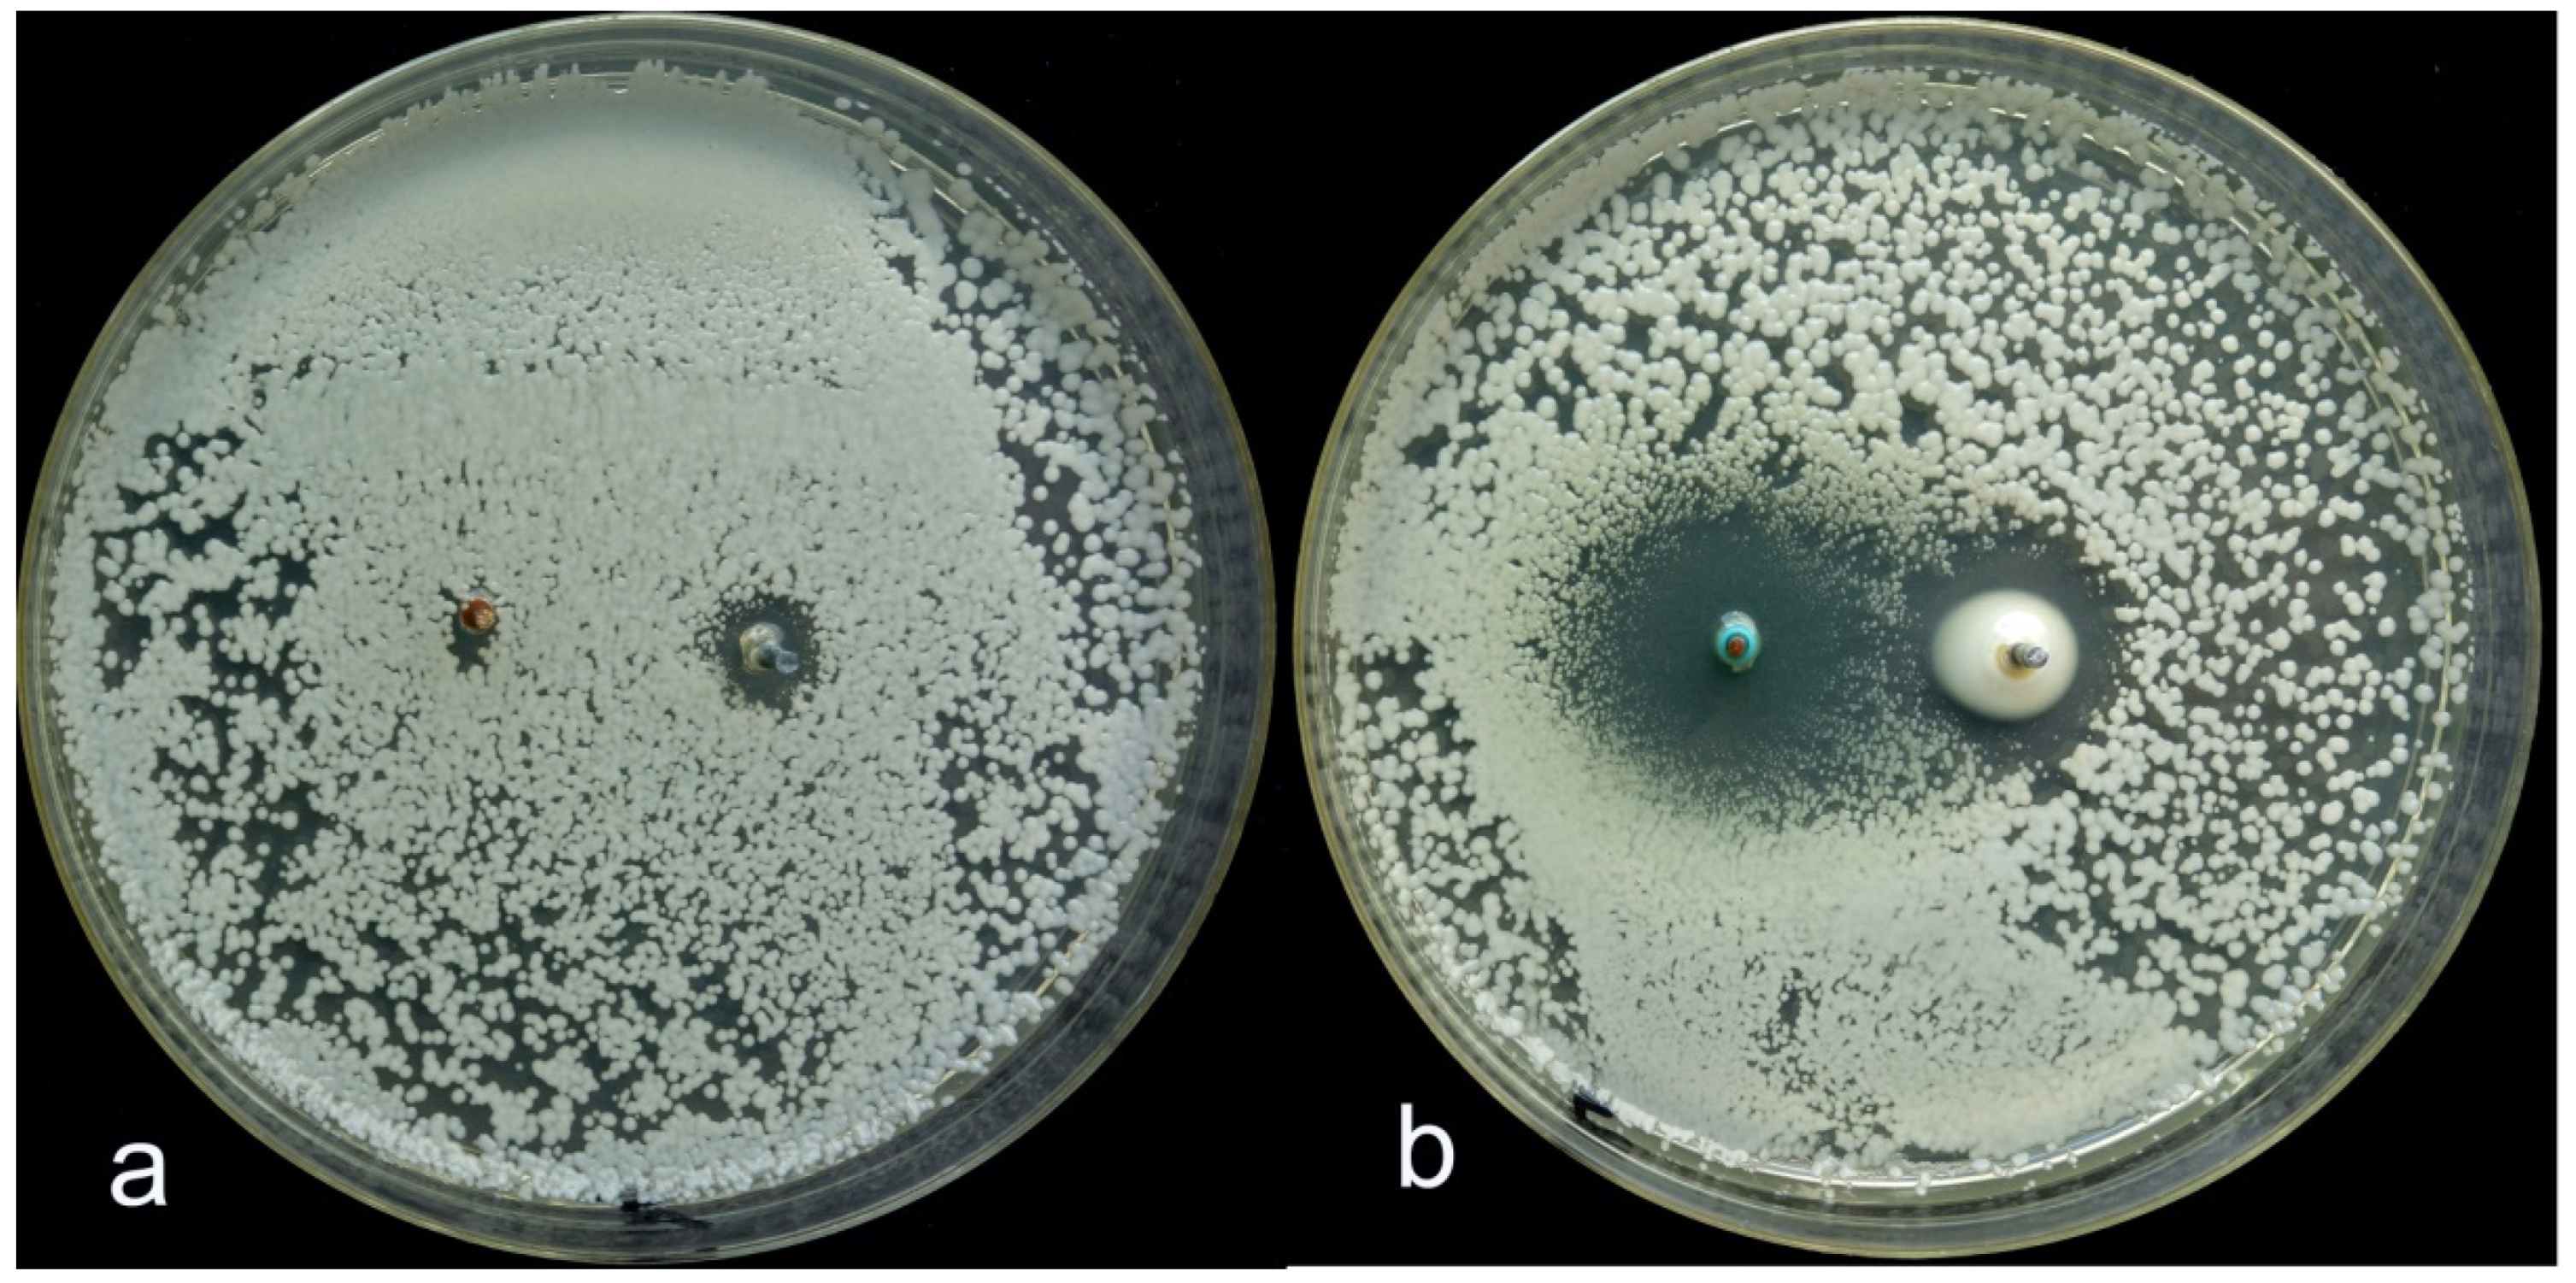

Electromagnetic Field as Agent Moving Bioactive Cations. A New Antimicrobial System in Architecture Technology
Abstract
Featured Application
Abstract
1. Introduction
2. Biofilms
3. GALVI Technology
4. Two-Phase Media
5. Possible Application of Galvanic Systems
Author Contributions
Funding
Institutional Review Board Statement
Informed Consent Statement
Data Availability Statement
Conflicts of Interest
References
- Adams, R.I.; Sylvain, I.; Spilak, M.P.; Taylor, J.W.; Waring, M.S.; Mendel, M.J. Fungal signature of moisture damage in buildings: Identyfication by target and untarget approaches with mycobiome data. Appl. Environ. Microbiol. 2020, 86, e01047-20. [Google Scholar] [CrossRef] [PubMed]
- Siegesmund, S.; Török, Á. Building Stones. In Stone in Architecture; Siegesmund, S., Snethlage, R., Eds.; Springer: Berlin/Heidelberg, Germany, 2014; pp. 11–95. [Google Scholar] [CrossRef]
- Embry, A.F.; Klovan, J.E. Absolute water depths limits of late Devonian paleoecological zones. Geol. Rundschau. 1972, 61, 672–686. [Google Scholar] [CrossRef]
- Flügel, E. Microfacies of Carbonate Rocks, Analysis, Interpretation and Application; Springer: New York, NY, USA, 2004; p. 976. [Google Scholar]
- Gadd, G.M. Fungi, rocks, and minerals. Elements 2017, 13, 171–176. [Google Scholar] [CrossRef]
- Sterflinger, K. Geomicrobiological Investigations on the Alteration of Marble Monuments by Dematiaceous Fungi (Sanctuary of Delos, Cyclades, Greece). Ph.D. Thesis, Universitety of Oldenburg, Oldenburg, Germany, 1995; p. 138. [Google Scholar]
- Wollenzien, U.; Hoog, G.S.; Krumbein, W.E.; Urzi, C. On the isolation of microbial fungi occurring on and in marble and other calcareous rocks. Sci. Total Environm. 1995, 167, 287–294. [Google Scholar] [CrossRef]
- Wollenzien, U.; Hoog, G.S.; Krumbein, W.E.; Ulithof, J.M.J. Sarcinomyces petricola, a new microcolonial fungus from marble in the Mediterranean basin. Anton Leeuw. Int. J. G. 1996, 71, 281–288. [Google Scholar] [CrossRef]
- Diakamaku, E.; Gorbushina, A.A.; Krumbein, W.E.; Panina, L.; Soukharjevski, S. Black fungi in marble and limestones—An aestetical, chemical, physical problem for the conservation of monuments. Sci. Total Environ. 1995, 167, 295–304. [Google Scholar] [CrossRef]
- Gorbushina, A.A.; Panina, L.K.; Vlasov, D.Y.; Krumbein, W.E. Fungi deteriorating marble in Chersonessus. Mikol. Fitopatol. 1996, 30, 23–27. [Google Scholar]
- Staley, J.T.; Palmer, F.E.; Adams, J.B. Microcolonial common inhabitants on desert rocks? Science 1982, 215, 1093–1095. [Google Scholar] [CrossRef]
- Sterflinger, K.; De Baere, R.; De Hoog, G.S.; De Wachter, R.; Krumbein, W.E.; Haase, G. Coniosporium perforans and Coniosporium apollinis, two new rock-inhabiting fungi isolated from marble in the Sanctuary of Delos (Cyclades, Greece). Antonie Leeuwenhoek 1997, 72, 349–363. [Google Scholar] [CrossRef]
- Sterflinger, K.; Krumbein, W.E. Dematiaceous fungi as a major agent of biopitting for Mediterranean marbles and limestnes. Geomicrobiol. J. 1997, 14, 219–230. [Google Scholar] [CrossRef]
- Ruibal, C.; Gueidan, C.; Selbman, L.; Gorbushina, A.A.; Crous, P.; Groenewald, J.Z.; Muggia, L.; Grube, M.; Isola, D.; Schoch, C.L.; et al. Phylogeny of rock-inhabiting fungi related to Dothideomycetes. Stud. Mycol. 2009, 64, 123–133. [Google Scholar] [CrossRef]
- Owczarek-Kościelniak, M.; Krzewicka, B.; Piątek, J.; Kapusta, P. Is there a link between the biological colonization of the gravestone and its decoloration? Int. Biodeterior. Biodegrad. 2020, 148, 104879. [Google Scholar] [CrossRef]
- Mehta, A.P.; Torma, A.E.; Murr, L.E. Effect of environmental parameters on the efficiency of biodegradation of basalt rock by fungi. Biotechnol. Bioenergy 1979, 21, 875–885. [Google Scholar] [CrossRef]
- Turian, G. Maxi-toxitolerance d’une Moissure-Dematiée algicorticole du genre Coniosporium. Ber. Schweiz. Bot. Ges. 1975, 85, 204–209. [Google Scholar]
- Blazquez, F.; Garcia-Vallez, M.; Krumbein, W.E.; Sterflinger, K.; Vendrell-Saz, M. Microstromatolitic deposits on granitic monuments: Development and decay. Eur. J. Mineral. 1997, 9, 889–901. [Google Scholar] [CrossRef]
- Braams, J. Ecological Studies of the Fungal Microflora Inhabiting Historical Sandstone Monuments. Ph.D. Thesis, University of Oldenburg, Oldenburng, Germany, 1992. [Google Scholar]
- Urzi, C.; Realini, M. Colour changes of Noto’s calcareous sandstone as related with its colonization by microorganisms. Int. Biodeterior. Biodegrad. 1998, 42, 45–54. [Google Scholar] [CrossRef]
- Chlebicki, A.; Zielenkiewicz, U.; Wilczek, A. Fungi are not involved in biofilm formation on rock wall in subterranean arsenic mine in Poland. Nova Hedwig. 2014, 99, 255–269. [Google Scholar] [CrossRef]
- Chlebicki, A.; Godzik, B.; Lorenc, M.W.; Skłodowska, A. Fungi and arsenic-tolerant Bacteria in the hypogean environment of an ancient gold mine in Lower Silesia SW Poland. Pol. Bot. Stud. 2005, 19, 81–95. [Google Scholar]
- Brandl, H. Heterotrophic Leaching. In Fungi in Bioremediation; Gadd, G.M., Ed.; Cambridge University Press: Cambridge, UK, 2001; pp. 383–423. [Google Scholar]
- Chlebicki, A.; Lorenc, M.W. The troglophile fungus, Physisporinus vitreus on a mine wall at Złoty Stok, Poland. Pol. Bot. J. 2006, 22, 149–154. [Google Scholar]
- Jongmans, A.G.; van Breemen, N.; Lundström, U.; van Hees, P.A.W.; Finlay, R.D.; Srinivasan, M.; Unestam, T.; Giesler, R.; Melkerud, P.A.; Olsson, M. Rock-eating fungi. Nature 1997, 389, 682–683. [Google Scholar] [CrossRef]
- Fomina, M.; Burford, E.P.; Hillier, S.; Kiernas, M.; Gadd, G.M. Rock-building fungi. Geomicrobiol. J. 2010, 27, 624–629. [Google Scholar] [CrossRef]
- Sterflinger, K.; De Hoog, G.S.; Haase, G. Phylogeny and ecology of meristematic ascomycetes. Stud. Mycol. 1999, 43, 5–22. [Google Scholar]
- Gueidan, C.; Ruibal, C.; de Hoog, G.S.; Schneider, H. Rock-inhabiting fungi originated during periods of dry climate in the late Devonian and middle Triassic. Fungal Biol. 2011, 115, 987–996. [Google Scholar] [CrossRef] [PubMed]
- Steiger, M.; Charola, E.; Sterflinger, K. Weathering and deterioration. In Stone in Architecture; Siegesmund, S., Snethlge, R., Eds.; Springer: Berlin/Heidelberg, Germany, 2014; pp. 225–316. [Google Scholar]
- Crispin, C.A.; Gaylarde, C.C. Cyanobacteria and biodeterioration of cultural heritage: A review. Microb. Ecol. 2005, 49, 1–9. [Google Scholar] [CrossRef] [PubMed]
- Canter Lund, H.; Lund, J.W.G. Freshwater Algae; Biopress Ltd.: Bristol, UK, 1998; p. 360. [Google Scholar]
- Gaylarde, C.C. Influence of Environment on Microbial Colonization of Historic Stone Buildings with Emphasis on Cyanobacteria. Heritage 2020, 3, 1469–1482. [Google Scholar] [CrossRef]
- Hindak, F.; Wołowski, K.; Hindakova, A. The epilithon of a cooling tower of the power plant at Bełchatów, Poland. Oceanol. Hydrobiol. Stud. 2011, 40, 38–43. [Google Scholar] [CrossRef][Green Version]
- García de Miguel, J.M.; Sánchez-Castillo, L.; Ortega-Calvo, J.J.; Gil, J.A.; Saiz-Jimenez, C. Deterioration of building materials from the Great Jaguar Pyramid at Tikal, Guatemala. Build. Environ. 1995, 30, 591–598. [Google Scholar] [CrossRef]
- Tripathi, S.N.; Tiwari, B.S.; Talpasayi, E.R.S. Growth of cyanobacteria (blue-green algae) on urban buildings. Energy Build. 1990, 15, 499–505. [Google Scholar] [CrossRef]
- Sterflinger, K. Fungi as geological agents. Geomicrobiol. J. 2000, 17, 97–124. [Google Scholar] [CrossRef]
- Ciferri, O.; Tiano, P.; Mastromei, G. Of Microbes and Art: The Role of Microbial Communities in the Degradation and Protection of Cultural Heritage; Kluwer Academic: Moscow, Russia, 2000; p. 250. ISBN 978-1-4613-6904-2. [Google Scholar] [CrossRef]
- Sand, W.; Bock, E. Biodeterioration of mineral materials by microorganisms—biogenic sulfuric and nitric acid corrosion of concrete and natural stone. Geomicrobiol. J. 1991, 9, 129–138. [Google Scholar] [CrossRef]
- Nielsen, K.F. Mould Growth on Building Materials. Secondary Metabolites, Mycotoxins and Biomarkers. Ph.D. Thesis, Danish Buking and Urban Research, Hørsholm, Denmark, 2002. [Google Scholar]
- Warscheid, T.; Braams, J. Biodeterioration of stone: A review. Int. Biodeterior. Biodegrad. 2000, 46, 343–368. [Google Scholar] [CrossRef]
- Dorniedent, T.; Gorbushina, A.A.; Krumbein, W.E. Anderungen der physikalischen Eigenschaften von Marmor durch Pilzbewuchs. Int. Bauinstandsetz. 1997, 3, 441–454. [Google Scholar]
- Sterflinger, K.; Gorbushina, A.A. Morphological and molecular characterisation of a rock inhabiting and rock decaying dematiaceous fungus isolated from antique monuments of Delos (Cyclades, Greece) and Chersonesus (Crimea, Ukraine). Syst. Appl. Microbiol. 1997, 20, 329–335. [Google Scholar] [CrossRef]
- Castanier, S.; Le Metayer-Levrel, G.; Orial, G.; Loubiere, J.-F.; Perthuisot, J.-P. Bacterial carbonatogenesis and applications to preservation and restoration of historic property. In Of Microbes and Art. The Role of Microbial Communities in the Degradation and Protection of Cultural Heritage; Ciferri, O., Tiano, P., Mastromei, G., Eds.; Springer: Boston, MA, USA, 2000; pp. 203–218. [Google Scholar]
- Eppard, M.; Krumbein, W.E.; Koch, C.; Rhiel, E.; Stanley, J.T.; Stackebrandt, E. Morphological, physiological and molecular characterization of actinomycetes isolated from dry soil, rocks, and monument surfaces. Arch. Microbiol. 1996, 166, 12–22. [Google Scholar] [CrossRef]
- Mottershead, D.; Gorbushina, A.A.; Lucas, G.; Wright, J. The influence of marine salt, aspect and microbes in the weathering of sandstone in two historic structures. Build. Environ. 2003, 38, 1193–1204. [Google Scholar] [CrossRef]
- Lansdown, A.B.G. Silver in health care: Antimicrobial effects and safety in use. Curr. Probl. Dermatol. 2006, 33, 17–34. [Google Scholar]
- Lorenc, M.W. Deterioracja obiektów kamiennych i metody jej zapobiegania. Biul. Inf. Konserw. Dzieł Szt. 2003, 14, 44–48. [Google Scholar]
- Macedo, M.F.; Miller, A.Z.; Dionísio, A.; Saiz-Jimenez, C. Biodiversity of cyano-bacteria and green algae on monuments in the Mediterranean Basin: An overview. Microbiology 2009, 155, 3476–3490. [Google Scholar] [CrossRef] [PubMed]
- Scott, J.A.; Untereiner, W.A.; Ewaze, O.J.; Doyle, D. Baudoinia, a new genus to accomodate Torula compniacensis. Mycologia 2007, 99, 592–601. [Google Scholar] [CrossRef] [PubMed]
- Isola, D.; Zucconi, L.; Onofri, S.; Caneva, G.; De Hoog, G.S.; Selbmann, L. Extremotolerant rock inhabiting black fungi from Italian monumental sites. Fungal Divers. 2016, 76, 75–96. [Google Scholar] [CrossRef]
- Urzi, C.; De Leo, F.; De Hoog, S.; Sterflinger, K. Recent advances in the molecular biology and ecophysiology of meristematic stone-inhabiing fungi. In Of Microbes and Art; Ciferri, O., Tiano, P., Mastromei, G., Eds.; Springer: Boston, MA, USA, 2000; pp. 3–19. [Google Scholar]
- Krumbein, W.E. Microbial interactions with mineral materials. In Biodeterioration; Houghton, D.R., Smith, R.N., Eggins, H.O., Eds.; Springer Science & Business Media: Dordrecht, The Netherlands, 2012; Volume 7, pp. 78–100. [Google Scholar]
- Krumbein, W.E.; Urzi, C.; Gehrmann, C. On the biocorrosion and biodeterioration of antique and medieval glass. Geomicrobiol. J. 1991, 9, 139–160. [Google Scholar] [CrossRef]
- Fassatiova, O. Micromycetes inhabiting the mines of Přibram (Czechoslovakia). Česka Mykol. 1970, 24, 162–165. [Google Scholar]
- Seves, A.M.; Sora, S.; Ciferri, O. The microbial colonization of oil paintings. A laboratory investigation. Int. Biodeter. Biodegrad. 1996, 37, 215–224. [Google Scholar] [CrossRef]
- De Hoog, G.S. Ecology and evolution of black yeasts and their relatives. Stud. Mycol. 1999, 43, 1–208. [Google Scholar]
- Ewaze, J.O.; Summerbell, R.C.; Scott, J.A. Physiological studies of the warehouse staining fungus, Baudoinia compniacensis. Mycol. Res. 2007, 111, 1422–1430. [Google Scholar] [CrossRef] [PubMed]
- Saarela, M.; Alakomi, H.L.; Suihko, M.L.; Maunuksel, L.; Raaska, L.; Mattilla-Sandholm, T. Heterotrofic microorganisms in air and biofilm samples from Roman catacombs, with special emphasis on actinobacteria and fungi. Int. Biodeterior. Biodegrad. 2004, 54, 27–37. [Google Scholar] [CrossRef]
- McMullin, D.; Sumarah, M.; Miller, D. Chaetoglobosins and azaphilones produced by Canadian strains of Chaetomium globosum isolated from the indoor environment. Mycotoxin Res. 2013, 29, 47–54. [Google Scholar] [CrossRef] [PubMed]
- Seyedmousavi, S.; Badali, H.; Chlebicki, A.; Zhao, J.; Prenafeta-Boldú, F.X.; de Hoog, G.S. Exophiala sideris, a novel black yeast isolated from environments polluted with toxic alkyl benzenes and arsenic. Fungal Biol. 2011, 115, 1030–1037. [Google Scholar] [CrossRef] [PubMed]
- Tribe, H.T.; Thines, E.; Weber, R.W.S. Moulds that should be better known: The wine cellar mould. Mycologist 2006, 20, 171–175. [Google Scholar] [CrossRef]
- Chebicki, A.; Majewska, M. Zasmidium cellare in Poland. Acta Mycol. 2010, 45, 139–142. [Google Scholar]
- Sinhg, R.S.; Saini, G.K.; Kennedy, J.F. Pullulan: Microbial sources, production and applications. Carbohydr. Polym. 2008, 73, 515–531. [Google Scholar]
- Characklis, W.G.; Marshall, K.C. Biofilms; John Wiley & Sons Inc.: Hoboken, NJ, USA, 1990; p. 816. [Google Scholar]
- Konhauser, K. Introduction to Geomicrobiology; Blackwell Publishing: Hong Kong, China, 2007. [Google Scholar]
- Drewniak, Ł.; Skłodowska, A. Isolation and characterization of psychrotolerant arsenite-oxidizing bacterium from gold mine in Złoty Stok. Adv. Mat. Res. 2007, 20, 576. [Google Scholar]
- Drewniak, Ł.; Styczek, A.; Skłodowska, A. Arsenic hypertolerant bacteria isolated from gold mine rocks biofilms. Adv. Mat. Res. 2007, 20, 575. [Google Scholar]
- Tomczyk-Żak, K.; Kaczanowski, S.; Drewniak, Ł.; Dmoch, Ł.; Skłodowska, A.; Zielenkiewicz, U. Bacteria diversity and arsenic mobilization in rock biofilm from anancient gold and arsenic mine. Sci. Total Environ. 2013, 461–462, 330–340. [Google Scholar] [CrossRef] [PubMed]
- Savoca, S.; Lo Giudice, A.; Papale, M.; Mangano, S.; Caruso, C.; Spanò, N.; Michaud, L.; Rizzo, C. Antarctic sponges from the Terra Nova Bay (Ross Sea) host a diversified bacterial community. Sci. Rep. 2019, 9, 1–15. [Google Scholar] [CrossRef] [PubMed]
- Luo, H.; Moran, M.A. Evolutionary ecology of the marine Roseobacter clade. Microbiol. Mol. Biol. Rev. 2014, 78, 573–587. [Google Scholar] [CrossRef] [PubMed]
- De Leo, F.; Marchetta, A.; Capillo, G.; Germanà, A.; Primerano, P.; Schiavo, S.L.; Urzì, C. Surface active ionic liquids based coatings as subaerial anti-biofilms for stone built cultural heritage. Coatings 2021, 11, 1–22. [Google Scholar]
- Miao, L.; Wang, C.; Adyel, T.M.; Zhao, J.; Yan, N.; Wu, J.; Hou, J. Periphytic biofilm formation on natural and artificial substrates: Comparison of microbial compositions, interactions, and functions. Front. Microbiol. 2021, 12, 684903. [Google Scholar] [CrossRef] [PubMed]
- Fisher, M.C.; Hawkins, N.J.; Sanglard, D.; Gurr, S.J. Worldwide emergence of resistance to antifungal drugs challenges human health and food security. Science 2018, 360, 739–742. [Google Scholar] [CrossRef]
- Snethlage, R. Stone conservation. In Stone in Architecture; Siegesmund, S., Snethlage, R., Eds.; Springer: Berlin/Heidelberg, Germany, 2014; Volume 7, pp. 415–550. [Google Scholar]
- Koo, H.; Allan, R.N.; Howlin, R.P.; Stoodley, P.; Hall-Stoodley, L. Targeting microbial biofilms: Current and prospective therapeutic strategies. Nat. Rev. Microbiol. 2017, 15, 740–755. [Google Scholar] [CrossRef]
- Gadd, G.M. Effect of copper on Aureobasidium pullulns in solid medium: Adptation not necessary for tolerant behaviour. Trans. Br. Mycol. Soc. 1984, 82, 546–549. [Google Scholar] [CrossRef]
- Gadd, G.M. Interactions of fungi with toxic metals. New Phytol. 1993, 124, 25–60. [Google Scholar] [CrossRef]
- Gadd, G.M.; Griffiths, A.J. Microorganisms and heavy metal toxicity. Microb. Ecol. 1978, 4, 303–317. [Google Scholar] [CrossRef] [PubMed]
- Nickerson, W.J. Inhibition of fungus respiration: A metabolic bioassay method. Science 1946, 103, 484–486. [Google Scholar] [CrossRef] [PubMed]
- Smith, W.H.; Staskawicz, B.J.; Harkov, R.S. Trace-metal pollutants and urban-tree leaf pathogens. Trans. Br. Mycol. Soc. 1978, 70, 29–33. [Google Scholar] [CrossRef]
- Somers, E. The fungi toxicity of metal ions. Ann. Appl. Biol. 1961, 49, 246–253. [Google Scholar] [CrossRef]
- Spisak, W.; Chlebicki, A.; Kaszczyszyn, M. Galvanic microcells as control agent of indoor microorganisms. Sci. Rep. 2016, 6, 35847. [Google Scholar] [CrossRef]
- Spisak, W.; Chlebicki, A.; Kaszczyszyn, M.; Szar, M.; Kozak, J.; Olma, A. Three-electrode galvanic microcells as a new antimicrobial tool. Sci. Rep. 2020, 10, 7341. [Google Scholar] [CrossRef]
- Babich, H.; Stotzky, G. Toxicity of Zinc to Fungi, Bacteria, and Coliphages: Influence of Chloride Ions. Appl. Environ. Microbiol. 1978, 36, 906–914. [Google Scholar] [CrossRef]
- Kraemer, H. The oligodynamic action of copper foil on certain intestinal organisms. Proc. Am. Phil. Soc. 1905, 44, 51–65. [Google Scholar]
- Ametrano, C.G.; Selbmann, L.; Muggia, L. A standardized approach for co-culturing dothidealean rock-inhabiting fungi and lichen photobionts in vitro. Symbiosis 2017, 73, 1–10. [Google Scholar] [CrossRef]
- Mirocha, C.J.; DeVay, J.E. Growth of fungi on an inorganic medium. Can. J. Microbiol. 1971, 17, 1373–1378. [Google Scholar] [CrossRef] [PubMed]
- Neilands, J.B. Microbial iron compounds. Ann. Rev. Biochem. 1981, 50, 715–731. [Google Scholar] [CrossRef] [PubMed]
- Sayer, J.A.; Kierans, M.; Gadd, G.M. Solublization of some naturally occurring metal-bearing minerals, limescale and lead phosphate by Aspergillus niger. FEMS Microbiol. Lett. 1997, 154, 29–35. [Google Scholar] [CrossRef] [PubMed]
- Gharieb, M.M.; Gadd, G.M. Influence of nitrogen source on the solublization of natural gypsum (CaSO4.2H2O) and the formation of calcium oxalate by different oxalic and nitric acid-producing fungi. Mycol. Res. 1999, 103, 473–481. [Google Scholar] [CrossRef]
- Scholz, M. Coagulation and flocculation. In Wetland Systems to Control Urban Runoff; Scholz, M., Ed.; Elsevier Science & Technology: Edinburgh, UK, 2006; pp. 43–50. [Google Scholar]
- Gadd, G.M. Metal Transformation. In Fungi in Bioremediation; Gadd, G.M., Ed.; Cambridge University Press: Cambridge, UK, 2001; pp. 359–382. [Google Scholar]
- Dziedzic, K.; Kozłowski, S.; Majerowicz, A.; Sawicki, L. (Eds.) Surowce mineralne Dolnego Śląska, Zakład Imienia Ossolińskich Wydawnictwo; Polskiej Akademii Nauk: Wrocław, Poland, 1979; p. 510. [Google Scholar]
- Kozłowski, S. Surowce Skalne Polski; Wydawnictwa Geologiczne: Warszawa, Poland, 1975; p. 344. [Google Scholar]
- Ryka, W.; Maliszewska, A. Słownik Petrograficzny; Wydawnictwa Geologiczne: Warszawa, Poland, 1982; p. 403. [Google Scholar]

| Name of Species | Citation | Kind of Substratum | Climate |
|---|---|---|---|
| Chroococcus sp. Chlorococcus sp. | [30,31] | historic church in Porto Alegre, RS, Brazil Europe, UK. Historical building Windermere | Tropical Moderate |
| Fischerella sp., Gloeocapsa, | [32] | cyanobacteria from external stone walls, Mexico | Equatorial and subequatorial zone |
| Leptolyngbya gracillima | [33] | cooling tower of the power plant at Bełchatów, Poland | Moderata |
| Scytonema myochrous | [33] | cooling tower of the power plant at Bełchatów, Poland; | Moderate |
| Scytonema sp. | [34] | limestone walls at other low-pollution sites, the Great Jaguar Pyramid at Tikal, Guatemala | Equatorial and subequatorial zone |
| Gloeothece rupestris | [33] | wall of the cooling tower of the power plant et Bełchatow | Moderate |
| Nostoc sp., Gloeothece rupestris (Lyngbye) | [33] | wall of the cooling tower of the power plant at Bełchatów | Moderate |
| Trentepohlia sp. | [32] | stone altar in the architectural zone of Becan, Campeche state, Mexico | Tropical |
| Gloecapsa sp. Gloeothece, Aphanocapsa, and Chroococcus, and filamentous species like Scytonema and Tolypothrix. | [35] | on urban building surfaces | Tropics |
| Name of Fungi | Citations | Kind of Substratum | Climate |
|---|---|---|---|
| Alternaria | very common | gypsum, tombstone, damp buildings | widely distributed |
| Aspergillus | very common | walls | widely distributed |
| Aureobasidium | common, [15,56] | marble, damp buildings | widely distributed |
| Baudoinia | [50,57] | buildings, cars | temperate |
| Beauveria | [58] | biofilm in Roman catacombs | mediterranean |
| Botryomyces | [8] | stone monuments | mediterranean |
| Chaetomium | [1,59] | damp buildings | temperate |
| Cladosporium | very common | damp buildings, tombstone | widely distributed |
| Constantinomyces | [15] | tombstone | temperate |
| Epicoccum | [1] | damp buildings | widely distributed |
| Exophiala | [15,60] | gold mine, tombstones | temperate |
| Geomyces | [21] | gold mine | temperate |
| Hortea | [29] | marble, monuments Delos island | mediterranean |
| Knufia | [15,56] | marble, monuments, tombstone | temperate, mediterranean |
| Lecanicillium | [58] | biofilm in Roman catacombs | mediterranean |
| Neocatenulostroma | [15] | tombstone | temperate |
| Neodevresia | [15] | tombstone | temperate |
| Penicillium | very common | damp buildings | widely distributed |
| Phoma | very common | damp buildings | widely distributed |
| Rhizopus stolonifer | Ref. [1], Chlebicki personal inf. | damp wall after flood, packing houses | widely distributed |
| Rhodotorula | [15,39] | paints, tombstone | widely distributed |
| Sarcinomyces | [8] | marble | mediterrenean |
| Stachybotrys | very common | gypsum | temperate |
| Torrubiella | [58] | biofilm in Roman catacombs | mediterranean |
| Trichoderma | very common | damp buildings, tombstone | widely distributed |
| Trimmatostroma | [29] | rock | temperate |
| Zasmidium | [61,62] | vine cellar wall | temperate |
Publisher’s Note: MDPI stays neutral with regard to jurisdictional claims in published maps and institutional affiliations. |
© 2021 by the authors. Licensee MDPI, Basel, Switzerland. This article is an open access article distributed under the terms and conditions of the Creative Commons Attribution (CC BY) license (https://creativecommons.org/licenses/by/4.0/).
Share and Cite
Chlebicki, A.; Spisak, W.; Lorenc, M.W.; Śliwa, L.; Wołowski, K. Electromagnetic Field as Agent Moving Bioactive Cations. A New Antimicrobial System in Architecture Technology. Appl. Sci. 2021, 11, 8320. https://doi.org/10.3390/app11188320
Chlebicki A, Spisak W, Lorenc MW, Śliwa L, Wołowski K. Electromagnetic Field as Agent Moving Bioactive Cations. A New Antimicrobial System in Architecture Technology. Applied Sciences. 2021; 11(18):8320. https://doi.org/10.3390/app11188320
Chicago/Turabian StyleChlebicki, Andrzej, Wojciech Spisak, Marek W. Lorenc, Lucyna Śliwa, and Konrad Wołowski. 2021. "Electromagnetic Field as Agent Moving Bioactive Cations. A New Antimicrobial System in Architecture Technology" Applied Sciences 11, no. 18: 8320. https://doi.org/10.3390/app11188320
APA StyleChlebicki, A., Spisak, W., Lorenc, M. W., Śliwa, L., & Wołowski, K. (2021). Electromagnetic Field as Agent Moving Bioactive Cations. A New Antimicrobial System in Architecture Technology. Applied Sciences, 11(18), 8320. https://doi.org/10.3390/app11188320

